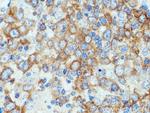
TNIP1 Antibody in Immunohistochemistry (Paraffin) (IHC (P))

Search
Proteintech
TNIP1 Polyclonal Antibody
{{$productOrderCtrl.translations['antibody.pdp.commerceCard.promotion.promotions']}}
{{$productOrderCtrl.translations['antibody.pdp.commerceCard.promotion.viewpromo']}}
{{$productOrderCtrl.translations['antibody.pdp.commerceCard.promotion.promocode']}}: {{promo.promoCode}} {{promo.promoTitle}} {{promo.promoDescription}}. {{$productOrderCtrl.translations['antibody.pdp.commerceCard.promotion.learnmore']}}
产品信息
15104-1-AP
种属反应
已发表种属
宿主/亚型
分类
类型
抗原
偶联物
形式
浓度
规格
纯化类型
保存液
内含物
保存条件
运输条件
产品详细信息
Immunogen sequence: AGKVPEVVA LGAAEKKVKM LEQQRSELLE VNKQWDQHFR SMKQQYEQKI TELRQKLADL QKQVTDLEAE REQKQRDFDR KLLLAKSKIE MEETDKEQLT AEAKELRQKV KYLQDQLSPL TRQREYQEKE IQRLNKALEE ALSIQTPPSS PPTAFGSPEG AGALLRKQEL VTQNELLKQQ VKIFEEDFQR ERSDRERMNE EKEELKKQVE KLQAQVTLSN AQLKAFKDEE KAREALRQQK RKAKASGERY HVEPHPEHLC GAYPYAYPPM PAMVPHHGFE DWSQIRYPPP PMAMEHPPPL PNSRLFHLPE YTWRLPCGGV RNPNQSSQVM DPPTARPTEP ESPKNDREGP Q (287-636 aa encoded by BC014008)
靶标信息
Grasp65 is a structural protein of the golgi apparatus. It has been implicated in the stacking of golgi cisternae. Grasp65 is shown to have the properties to bind surfaces together in a mitotically regulated matter.
仅用于科研。不用于诊断过程。未经明确授权不得转售。
生物信息学
蛋白别名: A20-binding inhibitor of NF-kappa B activation; A20-binding inhibitor of NF-kappa-B activation 1; ABIN; ABIN-1; HIV-1 Nef-interacting protein; hVAN; KIAA0113; Naf1; Nef-associated factor 1; Nef-associated factor 1 SNP; Nip40-1; ORF from anonymous craniofacial cDNA clone; Method: conceptual translation supplied by author.; TNFAIP3-interacting protein 1; unnamed protein product; VAN; Virion-associated nuclear shuttling protein
基因别名: ABIN; ABIN-1; ABIN1; AU018810; KIAA0113; NAF1; Nef; nip40-1; TNIP1; VAN
UniProt ID: (Human) Q15025, (Mouse) Q9WUU8
Entrez Gene ID: (Human) 10318, (Mouse) 57783